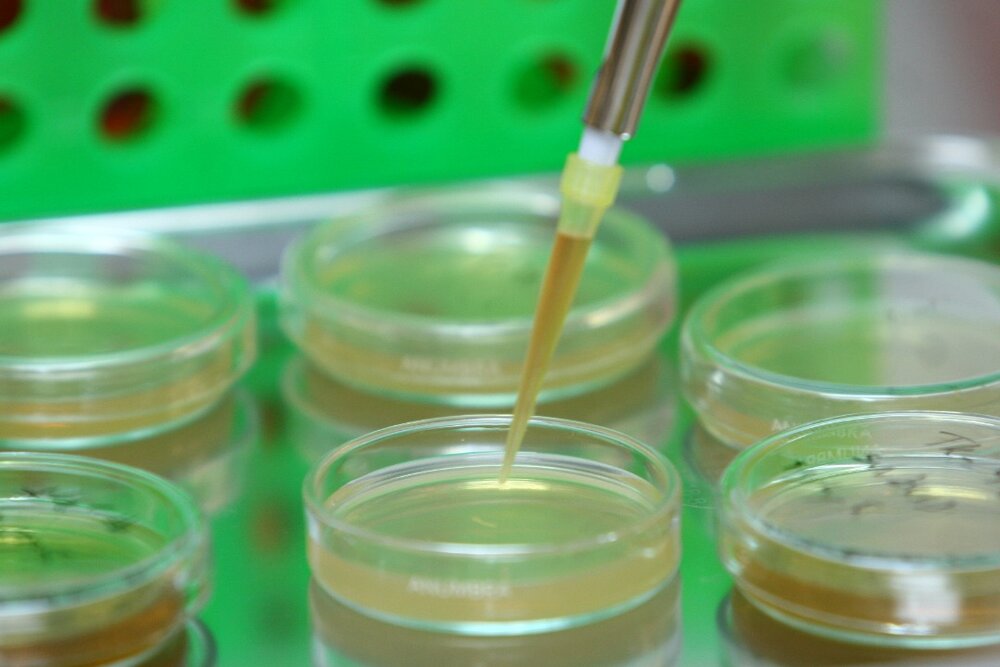
همکاری برای ورود فعالیتهای بانک ژنتیک به فرایندهای عمومی

به گزارش پایگاه خبری خلیج پرس، محمد کاظمی فرد امروز یکشنبه ۳۰ آبان، در جلسه شورای مدیران سازمان پزشکی قانونی کشور گفت: در مجموعه قوه قضائیه و سازمانهای تابعه هدف، ارائه خدمت مناسب به مردم است و مجموعه فناوری اطلاعات نیز در این راستا به دستگاههای زیر مجموعه کمکهای لازم را خواهد داشت.
وی با اشاره به تلاشهای صورت گرفته برای ارائه خدمات الکترونیک به مردم در راستای خدمت رسانی بهتر و سریعتر، اظهار داشت: ۷۰ درصد برنامهها، تکالیف و اهداف سند تحول قضائی فناوری پایه است و در بحث فناوریهای نوین به شدت علاقه مند به ارتباط و تعامل مستمر با سازمان پزشکی قانونی کشور هستیم.
کاظمی فرد ادامه داد: با همکاری و تعامل هرچه بیشتر پزشکی قانونی و مرکز فناوری اطلاعات قوه، در موضوع بانک اطلاعات هویت ژنتیک که سازمان پزشکی قانونی کشور متولی و مجری آن است، میتوان تحولات و اقدامات جدی را انجام داد از جمله اینکه فعالیت بانک را از بحث مجرمین خطرناک فراتر برده و وارد فرایندهای عمومی کنیم.
وی همچنین با تأیید برخی مشکلات در ارتباط الکترونیک بین دستگاهها و تأکید بر اهمیت زمان در انجام معاینات بالینی پزشکی قانونی خاطرنشان کرد: یکی از مشکلات مراکز پزشکی قانونی ارتباط با کلانتریها و ناجاست که کندی و قطعی مکرر سیستم ناجا مشکلاتی را در ارائه خدمت و پاسخ دهی به پروندهها ایجاد کرده است.
رئیس مرکز آمار و فناوری اطلاعات قوه قضائیه به جلسات مشترک با نیروی انتظامی برای بررسی و رفع این مشکل اشاره کرد و گفت: برای رفع این مشکلات و کندی ارتباط نیروی انتظامی با مجموعه قوه و از جمله پزشکی قانونی، به زودی کلیه ارتباطات و مکاتبات ناجا آنلاین خواهد شد که در این صورت سرعت ارائه خدمات افزایش یافته و مشکل تأخیر در پاسخ دهی برطرف میشود.
به گفته وی همچنین جلسهای در خصوص برخی کلانتریها که هنوز ارسال مکاتبات را به شکل فیزیکی انجام میدهند با نیروی انتظامی برگزار میشود تا زمینههای رفع این مشکل هم فراهم شود.
کاظمی فرد در بخش دیگری از سخنان خود با اشاره به توسعه خدمات الکترونیک قوه و تسهیل دسترسی به این خدمات افزود: با وزارت ارتباطات در حال مذاکره هستیم تا پنجره واحد قوه قضائیه را در زمینه ارائه خدمات ایجاد کنیم. در قالب این پنجره واحد خدماتی که توسط قوه قضائیه (ثنا محور) به مردم ارائه میشود در درگاه ملی قرار میگیرد تا متقاضیان با یکبار لاگین به همه خدمات قوه قضائیه دسترسی داشته باشند.
وی در ادامه با قول مساعد در خصوص بررسی و رسیدگی به مشکلات سازمان پزشکی قانونی در حوزه فناوری اطلاعات، در موضوعاتی همچون معاینه مجازی زندانیان در مواردی که نیاز به معاینه فیزیکی نیست، سیستم نوبت دهی آنلاین برای جلوگیری از ازدحام صبحگاهی مراکز، افزایش امنیت شبکه، آرشیو الکترونیک، ارتباط آنلاین با وزارت بهداشت برای مبادله پروندههای بیمارستانی و… قول همکاری و مساعدت داد و خواستار برگزاری جلسات مشترک ماهیانه با سازمان پزشکی قانونی کشور برای پیگیری و پاسخ دهی درخواستها شد.
هدف ما پاسخ دهی حتی یک ثانیه سریعتر به مراجعین است
در ادامه این جلسه عباس مسجدی رئیس سازمان پزشکی قانونی کشور، با اشاره به تلاشهای سازمان در راستای تحقق اهداف سند تحول قضائی در حوزه فناوری اطلاعات گفت: پزشکی قانونی به عنوان سازمانی فنی، تخصصی و خدمت رسان، نهایت تلاش خود را برای ارائه خدمت بی وقفه به مردم به کار میگیرد و حتی در دو سال گذشته برای جلوگیری از هرگونه نقص و خلل در ارائه خدمت به مردم از هیچ یک از بخشنامههای قوه قضائیه و دولت برای دورکاری و یا محدودیت حضور استفاده نکرد.
وی با اشاره به وجود مشکلاتی در برخی استانها در حوزه فناوری اطلاعات و سخت افزار، افزود: مراجعین پزشکی قانونی افرادی متألم، دردمند و آسیب دیده هستند که با شرایط روحی و روانی نامناسب به مراکز پزشکی قانونی مراجعه میکنند بنابراین پاسخ دهی سریع و معطلی کمتر آنان در پزشکی قانونی برای ما یک اصل و هدف مهم است.
مسجدی تقویت زیرساختهای فناوری اطلاعات و توسعه خدمات و ارتباطات الکترونیک را یکی از راهکارهای پاسخ دهی سریعتر به مردم عنوان و تصریح کرد: هرچند مجموعه قوه قضائیه با مشکلات و کمبودهای زیادی در حوزه زیرساختها و فناوری اطلاعات مواجه است اما درخواست ما آن است که سازمان پزشکی قانونی کشور به دلیل نوع ارجاعات آن و تألم و دردمندی مراجعان به طور ویژه مورد توجه قرار گیرد تا مردمی که به دلیل از دست دادن عزیزان خود و یا وقوع تصادف، نزاع و یا هر حادثه دیگری به این سازمان مراجعه میکنند سریعتر پاسخ استعلامشان را دریافت کنند.
وی با اظهار امیدواری در خصوص توسعه مناسب خدمات در بستر فناوری اطلاعات و فراهم شدن زمینه خدمت رسانی بهتر به مردم افزود: با وجود مشکلات و کمبودهای موجود، سازمان تمام تلاش خود را برای رفع مشکلات مالی و موانع قانونی به کار گرفته و بسیاری از مراکز استانها را به سخت افزارهای مورد نیاز تجهیز کرده اما هنوز بسیاری مراکز شهرستانی ما در این حوزه دچار مشکل و کمبود هستند.
مسجدی بار دیگر با اشاره به نوع ارجاعات پزشکی قانونی و دردمندی مراجعین این سازمان افزود: هرگونه مساعدت و همکاری برای تسهیل در ارائه خدمت به مردم به نفع مردم، کشور، مجموعه دستگاه قضائی و سازمان پزشکی قانونی کشور خواهد بود.
نرم افزار تخصصی معاینات در کل کشور به مرحله عملیاتی است
در این جلسه رضا حاج منوچهری معاون توسعه مدیریت و پشتیبانی سازمان نیز با اشاره به اجرای اتوماسیون تخصصی در سازمان به عنوان بزرگترین پروژه حوزه فناوری اطلاعات گفت: اتوماسیون تخصصی در حال حاضر در سراسر کشور در حوزه معاینات بالینی که بیشترین حجم عملکردی سازمان را در بر میگیرد، به شکل عملیاتی در حال اجرا است.
وی افزود: در بخشهای تخصصی دیگر (کمیسیون، تشریح و آزمایشگاه) اتوماسیون تخصصی به زودی اجرایی و عملیاتی خواهد شد که در حوزه تشریح قسمت اعظم کار انجام شده و در حال حاضر در چند استان به صورت آزمایشی در حال بهره برداری است.
حاج منوچهری با اشاره به فواید اتوماسیون تخصصی در موضوع پیشگیری از جعل و نیز افزایش سرعت و دقت در ارائه خدمات، مهمترین مشکل در استفاده از آن را قطعی مکرر CMS و مشکلات ارتباط با ناجا عنوان کرد و گفت: طی پیگیریهای انجام شده توسط قوه قضائیه و همکاری نیروی انتظامی بحث حذف CMS و ارتباط مستقیم با ناجا مطرح شده که در برخی استانها انجام شده و اجرای سراسری آن مشکلات کندی ارائه خدمات در قالب اتوماسیون تخصصی را رفع میکند.
معاون توسعه سازمان همچنین ارتباط مستقیم با قوه قضائیه و خارج از CMS را نیز در تسریع فرایندها بسیار مؤثر دانست و خواستار مساعدت در این زمینه شد.
حاج منوچهری در این جلسه برخی درخواستهای دیگر سازمان برای تسهیل در ارائه خدمت به مردم همچون ارتباط با سامانه ثنا، نرم افزار صحرا، سیستم نوبت دهی داخلی، امنیت شبکه، آرشیو الکترونیک، تأمین سخت افزارها از جمله کامپیوتر و…. را مطرح و خواستار مساعدت در این موارد شد.
یادآور میشود در این جلسه مدیران کل استانهای یزد، خراسان رضوی و گلستان (که به صورت ویدئوکنفرانسی در جلسه حضور داشتند) و همچنین مدیرکل پزشکی قانونی استان تهران مسائل و مشکلات خود در حوزه فناوری اطلاعات مطرح کردند.
همکاری برای ورود فعالیتهای بانک ژنتیک به فرایندهای عمومی
به گزارش پایگاه خبری خلیج پرس، محمد کاظمی فرد امروز یکشنبه ۳۰ آبان، در جلسه شورای مدیران سازمان پزشکی قانونی کشور گفت: در مجموعه قوه قضائیه و سازمانهای تابعه هدف، ارائه خدمت مناسب به مردم است و مجموعه فناوری اطلاعات نیز در این راستا به دستگاههای زیر مجموعه کمکهای لازم را خواهد داشت. وی با […]
لینک کوتاه : https://khalijpress.ir/?p=56135
- ارسال توسط : احسان فدائی
- 18 بازدید
- دیدگاهها برای همکاری برای ورود فعالیتهای بانک ژنتیک به فرایندهای عمومی بسته هستند